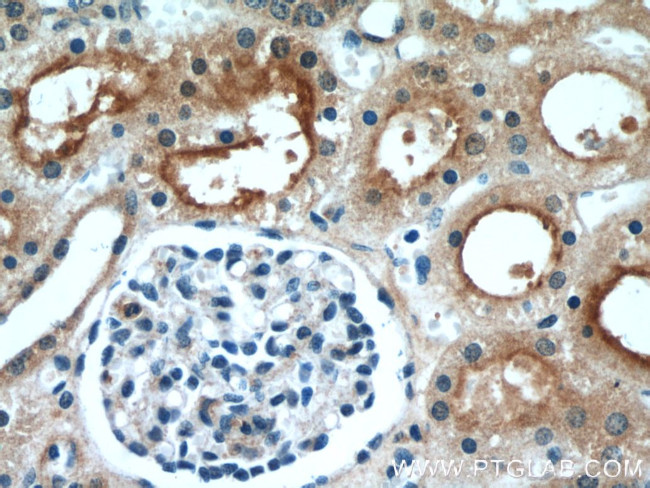
LNPEP Antibody in Immunohistochemistry (Paraffin) (IHC (P))
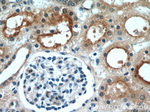
LNPEP Antibody in Immunohistochemistry (Paraffin) (IHC (P))
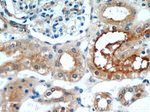
LNPEP Antibody in Immunohistochemistry (Paraffin) (IHC (P))

Search
Proteintech
LNPEP Polyclonal Antibody
{{$productOrderCtrl.translations['antibody.pdp.commerceCard.promotion.promotions']}}
{{$productOrderCtrl.translations['antibody.pdp.commerceCard.promotion.viewpromo']}}
{{$productOrderCtrl.translations['antibody.pdp.commerceCard.promotion.promocode']}}: {{promo.promoCode}} {{promo.promoTitle}} {{promo.promoDescription}}. {{$productOrderCtrl.translations['antibody.pdp.commerceCard.promotion.learnmore']}}
产品信息
55154-1-AP
种属反应
宿主/亚型
分类
类型
抗原
偶联物
形式
浓度
规格
纯化类型
保存液
内含物
保存条件
运输条件
产品详细信息
This antibody is specific to LNPEP.
靶标信息
This gene encodes a zinc-dependent aminopeptidase that cleaves vasopressin, oxytocin, lys-bradykinin, met-enkephalin, dynorphin A and other peptide hormones. The protein can be secreted in maternal serum, reside in intracellular vesicles with the insulin-responsive glucose transporter GLUT4, or form a type II integral membrane glycoprotein. The protein catalyzes the final step in the conversion of angiotensinogen to angiotensin IV (AT4) and is also a receptor for AT4. Alternative splicing results in multiple transcript variants encoding different isoforms.
仅用于科研。不用于诊断过程。未经明确授权不得转售。
篇参考文献 (0)
生物信息学
蛋白别名: angiotensin IV receptor; AT (4) receptor; Cystinyl aminopeptidase; insulin-regulated aminopeptidase; Insulin-regulated membrane aminopeptidase; Insulin-responsive aminopeptidase; IRAP; Leucyl-cystinyl aminopeptidase; OTase; Oxytocinase; P-LAP; Placental leucine aminopeptidase; unnamed protein product; vasopressinase; vp160
基因别名: CAP; IRAP; LNPEP; OTASE; P-LAP; PLAP
UniProt ID: (Human) Q9UIQ6
Entrez Gene ID: (Human) 4012